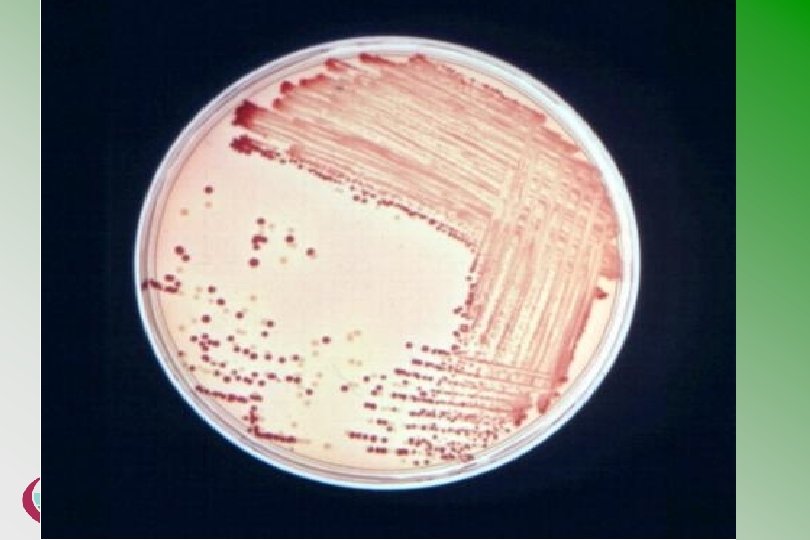

VT Escherichia coli O 157 in Wales What











































- Slides: 43

VT+ Escherichia coli O 157 in Wales: What have we learned ? Roland Salmon National Public Health Service for Wales Communicable Disease Surveillance Centre

VT+ Escherichia coli O 157 in Wales: What have we learned? • • • Structure VT+ Escherichia coli O 157. Surveillance in Wales. The 2005 South Wales outbreak. Lessons to be learned.

VT+ Escherichia coli O 157: “A new pathogen” • First case described 1977 Canada • First recognised outbreak 1982 USA • USA : Only 1/3, 000 archived stool specimens for period 1973 -1982 • UK: Only 2/15, 000 archived stools for period 1978 -1983

VT+ Escherichia coli O 157: “A new pathogen” • VT genes (1&2) – Integrated bacteriophage (ie originated as virus infection of the bacterium) • LEE – Island of pathogenicity on bacterial genome (35 Kb) • Additional virulence traits – Plasmid (97 k. B)

Symptoms of VT+E. coli O 157 infection: Wales 1990 -2004 Symptoms n % Diarrhoea 492 77 Blood in stool 273 43 19 3 639 100 HUS TOTAL CASES

Surveillance of VT+E. coli O 157: Scotland &Wales: 1990 -2007

Reports of VTEC O 157 by age group: Wales: 1990 -2004

Outbreaks of VTEC O 157: Wales: 1990 -2005 1990 1991 1993 1995 1997 1999 2000 2005 Psychogeriatric ward 4 cases Day nursery 9 cases Butcher’s shop 8 cases Day nursery 49 cases EMI home 3 cases Open farm 24 cases Campsite 2 cases Prison 8 cases School meals 118 (157) cases Infants’ School 15 cases School & nursery 10 cases

The world’s largest outbreaks of VTEC O 157 Year 1996 2000 1993 1996 2006 1999 Place Sakai City Walkerton Vehicle or place of infection Cases School meals (radishes) 14, 153 c. 2, 300 Mains water Western US Hamburger chain C Scotland Cooked meats Morioka 1 ary School USA Spinach New York State 2005 S Wales Confirmed cases 2, 764 Well water (agricultural show) 921 732 279 220 199 116 Cooked meats 157 118 512


VTEC O 157 outbreak in South Wales 2005

VTEC O 157 outbreak in South Wales 2005 Descriptive Epidemiology Semi-structured interviews using standard questionnaires asking: • age, sex, residence, occupation • others living in the household, their ages and occupations • symptoms & date of onset and exposure to: • foods over the previous week (including meals taken outside the home) • water supply • animals, • young children • others with compatible symptoms • recreational settings posing a risk of spread (eg swimming pools).

VTEC O 157 outbreak in South Wales 2005 Analytical Epidemiology • Preliminary Case Control Study 18 primary School Cases from 1 st wave v 3 unmatched controls from registers of case’s school • Case Control Study of Supply of Meats to Schools • 22 “case” schools v 25 schools without cases • • Cohort Study of Food Preferences Cohort study of households with/without 2 ary spread

VTEC O 157 outbreak in South Wales 2005 Key Epidemiological Results • • 157 cases 118 were confirmed as VT+ E. coli O 157 (109 were PT 21/28 VT 2, 43 PFGE profile “C”) 43% males 57% females 73% were school aged children (3 – 18 years) 44 schools had primary cases 31 (20%) were admitted to hospital There was one death in a 5 year old boy.

VTEC O 157 outbreak in South Wales 2005 Key Epidemiological Results II • • All 8 initial cases ate school dinners compared with a 60% uptake across the area (p=0. 017) First adult case (f, 49 y) was school meals supervisor (“Widow of Hampstead”) 10/10 1 ary cases ate school dinners v 8/13 controls ate school dinners in first week of term (p<0. 05) 11/11 schools with early cases (onset before 17 September) were supplied with turkey by a single supplier compared with 12/17 schools without cases (p=0. 047)

Communicable Disease Report Weekly 2005; 15: (6 Oct) Environmental and Microbiological Results • • A single main supplier distributed cooked meats to the affected schools. Practices that could result in cross contamination at the supplier’s premises were the subject of enforcement action by the local authority on 19 th September 2005. E. coli O 157 was isolated from three samples of sliced cooked meat obtained from 3 schools. The strains in the meat samples were indistinguishable from those in cases.

Results sampling ready to eat foods from schools and the community Sample type No. of samples Samples taken from Result Beef 18 School canteen Negative 5 Others Negative 80 School canteen Negative 1 Other Negative 208 School canteen Negative 22 Other Negative Lamb 14 School canteen PT 21/28 VT 2 PFGE A PT 21/28 VT 2 PFGE C Pork 17 School canteen Negative Poultry 1 School canteen PT 21/28 VT 2 PFGE C Turkey 82 School canteen PT 21/28 VT 2 PFGE C x 2 11 Other Negative Yoghurt/desserts 4 School canteen Negative Sandwich fillings 2 School canteen Negative Chicken Ham

Results sampling premises John Tudor & Sons Bridgend Sample type No. of samples Samples submitted by Result Beef 7 Local Authorities Negative Chicken 10 Local Authorities Negative Ham 13 Local Authorities Negative Turkey 18 Local Authorities Negative Tray of faggots 1 Local Authority Negative Fresh mint 1 Local Authority Negative Prawn cocktail 1 Local Authority Negative Chicken curry 2 Local Authority Negative Quiche lorraine 1 Local Authority Negative Swabs/equipment/overalls etc 44 Local Authority Negative Swabs/equipment/overalls etc 332 South Wales Police Negative 107 South Wales Police PT 21/28 VT 2 PFGE C x 4 PT 21/28 VT 2 PFGE A x 1 Raw Meat Homogenised meat / surface swab / blood/defrost liquor

Colwinston • 3 community cases in Colwinston – Onset 30 th September, 8 th November, asymptomatic • Confirmed as indistinguishable isolates from main outbreak end November • No link to cold cooked meat supplied by John Tudor and Sons established

Results of animal sampling Sample submitted from No. of samples Samples taken from Result Farm A 31 Bovine Negative 60 Ovine 5 PT 1 VT -ve Farm B 71 Bovine 37 PT 34 VT-ve Farm C 10 Bovine Negative 10 Ovine 2 PT 1 VT-ve 195 Bovine 43 PT 21/28 VT 2 (9 indistinguishable Farm D (800 acre mixed) 14 Dec. PFGE) 105 Ovine Negative

Colwinston community Hendre Junior School Cooked meat 21/28 VT 2 C Human case 21/28 VT 2 C Case 21/28 VT 2 C x 2 Case 21/28 VT 2 T Via Hendre Infants school Ton Pentre Junior School Cooked meat 21/28 VT 2 C John Tudor & Sons Bridgend Raw meat 21/28 VT 2 C Raw meat 21/28 VT 2 X Via Penygraig Infants School Human case 21/28 VT 2 L Human case 21/28 VT 2 O Human case 32 VT 2 Human case 21/28 VT 2 Ax 3 Human case 21/28 VT 2 B Human case 21/28 VT 2 Cx 3 Human case 21/28 VT 2 Ex 3 Human case 32 VT 2 Via Abattoir JE Tudor & Sons Treorchy Farm D Colwinston Animal Faeces 21/28 VT 2 C Animal Faeces 21/28 VT 2 T Animal Faeces 21/28 VT 2 U Animal Faeces 21/28 VT 2 V Animal Faeces 21/28 VT 2 W Animal Faeces 21/28 VT 2 X Animal Faeces 21/28 VT 2 Y Animal Faeces 21/28 VT 2 ZZ Animal Faeces 21/28 VT 2 YY Glan Taf Infants School Cooked meat 21/28 VT 2 A Newtown Primary School Cooked meat 21/28 VT 2 C Oaklands Primary School Cooked meat 21/28 VT 2 C Human case 21/28 VT 2 Q

Friday 7 th September 2007 • William John Tudor given 12 -month prison sentence • Pleaded guilty to six counts of placing unsafe food on the market and one count of failing, as proprietor of a business, to protect food against the risk of contamination

VT+ Escherichia coli O 157: Routes of spread. Animal to human Direct via food Human to human Households Institutional settings

Sources of VTEC O 157: Casecontrol study: Wales 1994 -96 ( Parry et al: Lancet 1998; 351: 1019 -22

VT+ Escherichia coli O 157: Potential for pathogenic spread. 15. 4% cattle faeces; 0. 47% carcasses (abattoir), sheep, horses, deer, goats, dogs, geese, pigs, gulls Survives 12 mo. (cattle faeces) & 20 weeks (soil) Low infective dose (< 700 organisms) Documented spread: farmers, farmers’ children, farm visitors.

VT+ Escherichia coli O 157: Preventing animal to human spread. General Hand washing - after handling and before eating. Do not eat/smoke while attending animals or their waste. Keep shoes away from main living areas. Launder overalls separately. Advice to contractors Care of children (especially toddlers and crawlers)

VT+ Escherichia coli O 157: Preventing animal to human spread. Farms open to the public. Planning: anticipate and assess risks. Show only animals in good health. Keep eating areas away from animals. Signposting: animals>handwashing->eating. Sufficient and adequate handwashing facilities. Train staff to appreciate risks.

Case Control Study: Open Farm: North Wales 1999 Payne et al: Em In Dis 2003; 9: 526 -30

VT+ Escherichia coli O 157: Preventing spread via food. The well recognised lapses. 1. Failure to achieve adequate cooking temperatures. 2. Contamination of ready to eat products.

VT+ Escherichia coli O 157: Preventing spread via food. Addressing the well recognised lapses. 1. HACCP. 2. Clear and precise guidance from regulatory bodies supported by an enforcement framework for improving premises and practices. 3. Producers v Retailers v Caterers.

VT+ Escherichia coli O 157: Preventing spread via food. Novel aspects. 1. Low infectious dose. 2. Acid resistance. 3. Vehicles include radishes, salami, apple juice, soily potatoes, spinach. 4. Some/all(? ) had undergone “accepted” processing.

U. S. Developments • Minced Beef 2003 • Spinach & Lettuce 2008

VT+ Escherichia coli O 157: Preventing human to human spread. Index case Contacts Under 1 Age 1 -4 Age 5 -14 Age 15 -44 Age 45+ Total Under 1 0 0 0 Age 1 -4 50% 38% 33% 0 0 31% Age 5 -14 0 9% 0 0 0 4% Age 15 -44 33% 11% 12% 0 0 9% Age 45+ 0 0 0 Total 40% 17% 10% 0 0 8% Parry and Salmon Emerging Infect Dis 1998; 4: 657 -61.

Risk factors for households having a secondary case in a large outbreak of VTEC O 157 in Wales 2005 Not significant: male gender, primary case HUS/hospitalised, number of household contacts Werber D et al: Clinical Infectious Diseases 2008: 46: 1189 -96.

Number of days between symptom onset in primary and secondary case patients in a large outbreak of VT+ Escherichiacoli O 157 infection in South Wales, 2005 Werber D et al. Clinical Infectious Diseases 2008: 46: 1189 -96.

VT+ Escherichia coli O 157: Preventing human to human spread. • Prompt separation of paediatric patients with VTEC O 157 infection from their young siblings should be considered.

VT+ Escherichia coli O 157: Preventing human to human spread in institutions Adequate toilet facilities Hot running water, Soap, Hand drying facilities. Supervision Written cleaning and disinfection regimes The vexed question of exclusion “The following guidelines are somewhat categorical, but we recognise that, in practice, this area may require the exercise of considerable judgement”.

VT+ Escherichia coli O 157: Preventing human to human spread: exclusion. Who? Groups A to D. • Group A (4): Any person of doubtful personal hygiene or with unsatisfactory toilet, hand-washing or hand drying facilities at home, work or school. • Group B (3): Children who attend pre-school groups or nursery. • Group C (1): People whose work involves preparing or serving unwrapped foods not subjected to further heating. • Group D (2): Clinical and social care staff who have direct contact with highly susceptible patients or persons in whom a gastrointestinal infection would have particularly serious consequences. How long? After clinical recovery (passing “normal” stools) and 2 consecutive negative faecal specimens taken at least 48 hours apart.

www. hpa. org. uk/cdph/issues/ CDPHvol 3/No 1/vtec. pdf www. hpa. org. uk/cdph/issues/CDPH vol 7/No 4/guidelines 2_4_04. pdf

VT+ Escherichia coli O 157: Preventing human to human spread in institutions Al-Jader et al. Arch Dis Child 1999; 81: 60 -3

VT+ Escherichia coli O 157: Key tasks Animal to human. Education in the farm setting. Developing standards in farms open to the public. Engineering of private water supplies. Spread via food. Regulatory framework. Pasteurisation of milk (England Wales). Risk benefit analysis of food irradiation. Human to human Preventing institutional spread. Preventing household spread

What have we learned? “Groundhog Day” • “I just wondered if you care to comment whether you see yourself as Bill Murray in Ground Hog Day. As we've heard, you have presented much evidence based on your personal experience of E. coli O 157, and we've seen papers written by you extensively analysing the problem particularly in Wales, and yet we have an outbreak. Do you feel the same as me? ” • E. coli Inquiry 10 th March 2008